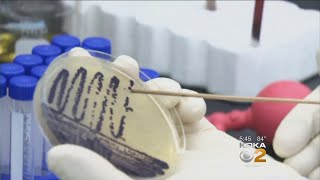

Exploring bacteria strains in cancer therapy video
Online izle ve mp4 mp3 formatlarinda yukle

Videonun muddeti: 0:44
Exploring bacteria strains in cancer therapy videosu mp4 ve mp3 yuklemek ucun hazirdir
Diqqet! Siz Mp4 yukle ve ya Mp3 yukle duymesine basdiqdan sonra eger sistem sizi reklam sehifesine atarsa o zaman derhal geri qayidib emeliyyati tekrar edin ve faylin yuklemek ucun hazir olmasini gozleyin
Videodan Mp4 Yukle
Videodan Mp3 Yukle-1
Videodan Mp3 Yukle-2
Oxshar Axtarishlar
 Exploring bacteria strains in cancer therapy
Exploring bacteria strains in cancer therapy Getting to the Gut of the Matter: Nutrition, Probiotics and Cancer
Getting to the Gut of the Matter: Nutrition, Probiotics and Cancer Exploring innovative ways to enhance the delivery of cancer therapy to brain tumours
Exploring innovative ways to enhance the delivery of cancer therapy to brain tumours CancerVAX is exploring a unique approach to cancer treatment
CancerVAX is exploring a unique approach to cancer treatment Navigating regulatory challenges for live bacteria in cancer therapy
Navigating regulatory challenges for live bacteria in cancer therapy Behind the Breakthrough: Dr. Xiang's Inspiration for Advancing Cancer Therapy
Behind the Breakthrough: Dr. Xiang's Inspiration for Advancing Cancer Therapy Engineering bacteria to enhance immunotherapy for cancer treatment
Engineering bacteria to enhance immunotherapy for cancer treatment Bioengineering - Treating cancer with engineered microbes
Bioengineering - Treating cancer with engineered microbes Researchers: Salmonella Strain Could Hold Key To Beating Cancer
Researchers: Salmonella Strain Could Hold Key To Beating Cancer
Video Mp4 Mp3Azwap.Biz
Azwap.Biz 2021-2023


 Exploring bacteria strains in cancer therapy
Exploring bacteria strains in cancer therapy Getting to the Gut of the Matter: Nutrition, Probiotics and Cancer
Getting to the Gut of the Matter: Nutrition, Probiotics and Cancer Exploring innovative ways to enhance the delivery of cancer therapy to brain tumours
Exploring innovative ways to enhance the delivery of cancer therapy to brain tumours CancerVAX is exploring a unique approach to cancer treatment
CancerVAX is exploring a unique approach to cancer treatment Navigating regulatory challenges for live bacteria in cancer therapy
Navigating regulatory challenges for live bacteria in cancer therapy Behind the Breakthrough: Dr. Xiang's Inspiration for Advancing Cancer Therapy
Behind the Breakthrough: Dr. Xiang's Inspiration for Advancing Cancer Therapy Engineering bacteria to enhance immunotherapy for cancer treatment
Engineering bacteria to enhance immunotherapy for cancer treatment Bioengineering - Treating cancer with engineered microbes
Bioengineering - Treating cancer with engineered microbes Researchers: Salmonella Strain Could Hold Key To Beating Cancer
Researchers: Salmonella Strain Could Hold Key To Beating Cancer